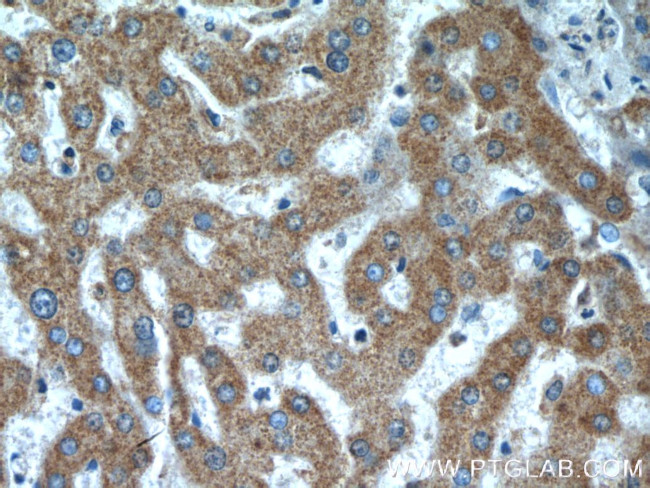
ANKZF1 Antibody in Immunohistochemistry (Paraffin) (IHC (P))

Search
Proteintech
ANKZF1 Polyclonal Antibody
{{$productOrderCtrl.translations['antibody.pdp.commerceCard.promotion.promotions']}}
{{$productOrderCtrl.translations['antibody.pdp.commerceCard.promotion.viewpromo']}}
{{$productOrderCtrl.translations['antibody.pdp.commerceCard.promotion.promocode']}}: {{promo.promoCode}} {{promo.promoTitle}} {{promo.promoDescription}}. {{$productOrderCtrl.translations['antibody.pdp.commerceCard.promotion.learnmore']}}
产品信息
20447-1-AP
种属反应
宿主/亚型
分类
类型
抗原
偶联物
形式
浓度
规格
纯化类型
保存液
内含物
保存条件
运输条件
产品详细信息
Immunogen sequence: TEEEIRKIC RDEKEALGQN EESPKQGSGS EGEDGFQVEL ELVELTVGTL DLCESEVLPK RRRRKRNKKE KSRDQEAGAH RTLLQQTQEE EPSTQSSQAV AAPLGPLLDE AKAPGQPELW NALLAACRAG DVGVLKLQLA PSPADPRVLS LLSAPLGSGG FTLLHAAAAA GRGSVVRLLL EAGADPTVQD SRARPPYTVA ADKSTRNEFR RFMEKNPDAY DYNKAQVPGP LTPEMEARQA TRKREQKAAR RQREEQQQRQ QEQEEREREE QRRFAALSDR EKRALAAERR LAAQLGAPTS PIPDSAIVNT RRCWSCGASL QGLTPFHYLD FSFCSTRCLQ DHRRQAGRPS S (377-726 aa encoded by BC000238)
靶标信息
Plays a role in the cellular response to hydrogen peroxide and in the maintenance of mitochondrial integrity under conditions of cellular stress (PubMed:28302725). Involved in the endoplasmic reticulum (ER)-associated degradation (ERAD) pathway. [UniProt]
仅用于科研。不用于诊断过程。未经明确授权不得转售。
生物信息学
蛋白别名: ankyrin repeat and zinc finger domain containing 1; Ankyrin repeat and zinc finger domain-containing protein 1; tRNA endonuclease ANKZF1; unnamed protein product; Zinc finger protein 744
基因别名: ANKZF1; Vms1; ZNF744
UniProt ID: (Human) Q9H8Y5
Entrez Gene ID: (Human) 55139